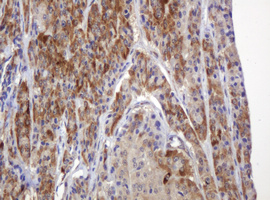
Immunohistochemical staining of paraffin-embedded Carcinoma of Human thyroid tissue using anti-TBC1D13 mouse monoclonal antibody. (Heat-induced epitope retrieval by 10mM citric buffer

HEK293T cells were transfected with the pCMV6-ENTRY control (Left lane) or pCMV6-ENTRY TBC1D13 (Right lane) cDNA for 48 hrs and lysed. Equivalent amounts of cell lysates (5 ug per lane) were separated by SDS-PAGE and immunoblotted with anti-TBC1D13.
Anti-TBC1D13 Mouse Monoclonal Antibody [Clone ID: OTI2C5]
M15731
ApplicationsWestern Blot, ImmunoHistoChemistry
Product group Antibodies
ReactivityHuman, Mouse, Rat
TargetTBC1D13
Overview
- SupplierBoster Bio
- Product NameAnti-TBC1D13 Mouse Monoclonal Antibody [Clone ID: OTI2C5]
- Delivery Days Customer9
- ApplicationsWestern Blot, ImmunoHistoChemistry
- CertificationResearch Use Only
- ClonalityMonoclonal
- Clone IDOTI2C5
- Concentration1 mg/ml
- Gene ID54662
- Target nameTBC1D13
- Target descriptionTBC1 domain family member 13
- Target synonymsTBC1 domain family member 13, epididymis secretory sperm binding protein
- HostMouse
- IsotypeIgG1
- Protein IDQ9NVG8
- Protein NameTBC1 domain family member 13
- Scientific DescriptionBoster Bio TBC1D13 mouse monoclonal antibody,clone OTI2C5. Catalog# M15731. Tested in IHC, WB. This antibody reacts with Human, Mouse, Rat.
- ReactivityHuman, Mouse, Rat
- Storage Instruction-20°C
- UNSPSC12352203